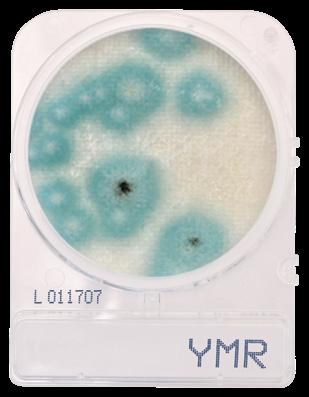

10 minute read
Product Revolution
Hitoki Trident — As the cannabis industry continues to evolve, so does the way we smoke. Hitoki is making a name for itself designing luxurious, high-tech cannabis products. Their new Trident is a patent-pending laser combustion smoking device. Its combustion method works like a magnifying glass under the sun, eliminating the need to use butane from a lighter. This technology creates a cleaner smoke that allows you to get a true taste of your flower. The Hitoki Trident comes in three fashionable colors: 24K Gold ($650), Black ($500), and
Rose Gold ($500).
Advertisement



PET CRC Compatible Jars by Alpha Packaging — Maintaining the quality and safety of cannabis requires specialized packaging. These polyethylene terephthalate (PET) jars are sleek, child-resistant, and can be made from 100% post-consumer (recycled) PET. Adult-use cannabis jars are available in 4-ounce, 6-ounce, and 8-ounce with a 70mm neck finish, as well as a 6-ounce with a 63mm finish. Jars can be blow molded in clear, transparent, or opaque colors. Select styles and colors are stocked at Alpha Packaging’s warehouse and are available by the case. Request a quote
through their website: https://www.alphap.com/request-a-quote/.
WaveWasher Ultrasonic 420 Cleaning Machine — There’s nothing worse than a dirty bong. Not only will your cannabis taste bad, but your bong could contain mold, mildew, and bacteria. WaveWasher is the first and only 420 dishwasher that cleans glass and removes residue quickly. Press the button on the Wave Washer and warm water will be blasted with ultrasonic sound waves to sanitize your equipment with 50-100% less isopropyl alcohol and no salt. Your bong and 420 smoking accessories will look great, and your lungs will thank you too. $250
DaVinci IQC — Be a trendsetter with the sleek and classy IQC vaporizer from DaVinci. Available in four vibrant colors, this vaporizer lives up to its namesake by looking like a work of art. The versatile vaporizer has advanced temperature control, app connectivity, replaceable and rechargeable battery, USB Type-C charging, and the ability to charge your phone on the go. The IQC additionally features precision temperature settings to 430°F / 221°C, 30-second heat up time, 0.5g oven capacity, and is heavy metals tested. $229

Get mobile with CannaCard
The CannaCard® helps dispensaries deliver their products in a safe, transparent and cashless manner.
The CannaCard App removes the need for cash from customer transactions, ensuring that both the delivery driver and consumer stay safe from nefarious elements. The CannaCard network and handheld mobile devices are capable of running 100,000 secure transactions per second over 5G LTE.
And, with additional options for fleet and vehicle tracking to local authorities, CannaCard can get products into the hands of your customers quickly and conveniently.
Hit the road with CannaTrac by contacting us today.


ACS Laboratory’s Tested Safe Certified Seals — Behind each proprietary ACS Seal is a Certificate of Analysis (COA) that features the results of every fullpanel test that your product received. The COA is also branded with the trademarked TESTED SAFE CERTIFIED SEAL, showing customers that your brand is transparent, accountable, and happy to share its ingredients. Available free
of charge to help create a more trustworthy industry.
Session Goods Bong — Session Goods’ bongs and accessories were crafted to eliminate the taboo nature of cannabis consumption with easy-to-use, beautiful smoking devices for every lifestyle. Made of 4mm thick borosilicate glass, this modern, sleek, designer bong could be mistaken for an art piece in your home. In fact, each bong sold in paradise, horizon, and moonlight colors is paired with an exclusive art print. The piece also includes two different bowls and an extra downstem. Sit back, relax, and smoke in style. $120


The Flower-Friendly Process by Rad Source Photonic Decontamination —
Don’t question your cannabis, be confident in your flower. Rad Source Technologies provides the cannabis industry with the only microbial remediation devices that use patented Quastar technology to inactivate 99.9% of harmful microbes while maintaining the integrity of the plant. The RS 420•XL Cannabis Decontamination System provides a true peace-of-mind cannabis remediation experience resulting in nominal-to-zero adverse effect to the flower. It’s time to pass state-mandated testing levels without worry. Call for pricing.
EnviroPro Air Handling Product Family by Surna Cultivation
Technologies — Temperature and humidity control is crucial when cultivating cannabis. With Surna’s new expanded line of curated HVAC products, cultivators can find energy-efficient options and DX systems for consistent and reliable cooling, heating, and dehumidifying solutions, all without burning a hole in your wallet. Fit your unique grow needs by checking out the EnviroPro DX HVACD units, custom DX air handles, custom-chilled water air handlers, and mini air handlers. Visit www.surna.com for pricing.




Keef Life H20 Cannabis Beverage — Keef Life H20 is the perfect beverage for any cannabis enthusiast who wants a refreshing, non-alcoholic buzz after a long day. Vegan, gluten free, and with only 1 gram of sugar per serving, it meets the needs of anyone focusing on their health. Each beverage contains 100mg THC and comes in cranberry lime (sativa), blueberry lemon (indica), and strawberry kiwi (hybrid). It’s perfect to mix with your favorite beverage or drink on its own. Bottoms up! Prices vary. Azuca Syrups from Everest Apothecary — There’s nothing like winding down with a hot cup of tea in the evening. Azuca Syrups kick your favorite beverage up a notch with their Azuca Time Infusion sweet syrup, which quickly creates a Delta-9 THC experience akin to smoking. Mix the delicious fast-acting syrup into any of your favorite beverages, like tea, seltzer, or coffee, and feel the effects in 2-15 minutes. $25 per bottle.



The MIGHTY PYTHON from Tom’s Tumbler — The Mighty Python exceeds expectations by offering a versatile, all-in-one, continuous feed, bladeless trimmer that dry trims, Cryo trims, sorts, and extracts kief. The Mighty Python can trim 400-600 lbs per hour with minimal loss of trichomes, terpenes, or flower structure. The Python can sort four different sized flowers and makes kiefing a breeze due to its 170 micron kief screen. Invented by a grower for growers, the Python was designed to meet the needs of any harvest. Call for pricing. Want a way to network with other cannabis professionals anywhere you go? The THC Girls App is the newest cannabis networking platform that directly connects ambassadors, influencers, and vendors. You can connect directly with vendors to expand your company or hire experienced ambassadors and influencers to showcase your products to the world. From your very own phone, the THC Girls app is your one-stop shop to build a world-class community. The
THC GIRLS app is FREE to download. The THC Girls Model membership is only $15 to $30 monthly and $25 yearly for vendors.


What is Pick•See?
Pick•See is a full-featured Field Service Management (FSM) Tool created from within the Retail Industry to address the particular needs of the Producers, Retailers, and Rep Agencies.
Pick•See makes field data reporting simple and allows you to go beyond traditional email, paper forms, and spreadsheets. Pick•See Web and Mobile Reports provide 24/7 access to online field data.
What Data Management and Reporting Solutions does Pick•See Provide?
Pick•See Reports and Forms: Create any audit or survey with photos and even signature capture. It can be used for daily Health and Safety checks.
Pick•See Geo-Tag Check-In: Provides the ultimate level of accountability for the mobile worker to their employer and the company to their clients. The Geotag IS NOT a tracker but a location/time stamp. It allows companies to KNOW their staff was on location, provides a layer of security and safety, and is invaluable for health contact tracing.
Pick•See Mobile: Pushes data reports and images from the field to the Pick•See Cloud and then pulls down any new tasks, lists, or forms – all in Real-Time!
Pick•See Portal: This allows you to share information from the field with your team or clients. View reports online or export data to spreadsheets, PDF documents, and even batches files of compressed images.
Pick•See Admin Tools: Provide a vast array of administrative, CRM, form, and file management functions built specifically for the retail sales and service industry.
Pick•See Financial Tools: Allow you to tie sales and revenues to store visits and service times for a complete ROI analysis. View reports on dashboards or create your own with our custom report builder.
While many other FSM providers can cost tens of thousands to set up, license, manage and train, you can have a Pick•See Solution set up for less than $10k. Monthly user fees max at $40 per person, training is included, and many support options are available. When you sign on with Pick•See, we don’t pass you off to a 3rd party ‘implementation’ company. We’re with you from the initial consultation through the setup, training, and dedicated support.
Competitors often have “minimum spends” and do not want your business if your budget is below it. Pick•See is affordable for any sized organization. Even if you have only one rep, you can access the Pick•See Hub and have the same features.
Pick•See does all its development and data storage domestically. Nothing is managed or stored offshore. As Pick•See is a Software as a Service (SaaS), when we make something new or make something better, you get something new and better, with nothing to download or install, it just happens.
As not all States have yet legalized the recreational use of cannabis, many of the big-name players are afraid to provide their services to the retail cannabis industry. Pick•See is here for you now. All you have to do is call 1.877.705.PICK (7425) or email info@pick-see.com.


IDENTITY Superfood Coffee Creamer — Take your mornings to the next level with a delicious, healthy, dairy-free, CBD-infused coffee creamer from wellness brand IDENTITY. Available in honey, vanilla, coconut, and cacao, these coffee creamers are made from organic ingredients and also soy-free and gluten-free with no artificial sweeteners nor THC, and are third-party tested. They can mix perfectly in teas, smoothies, dips, and desserts for a delicious twist. Each single serving creamer packet contains 10 mg of hemp CBD. $5.00 for a single serving packet. $45 for a 10 Pack. The Puffco Plus — The Plus Pen by Puffco is a perfect gift for any vape enthusiast who is always onthe-go. The Plus features a coil-free ceramic chamber, free from contaminants like glue or plastic, which ensures a faster heating time and terrific taste. The versatile mouthpiece of the Plus can also be used as a dart loader for portable use when packaging concentrates. The minimalist, sheek design of the Puffco Plus allows the vape pen to be both discrete and the life of the party. $90

CompactDry Yeast Mold Rapid by Hardy Diagnostics — Cannabis is medicine and no one wants a medicine that makes the consumer sick. Hardy Diagnostics’ CompactDry Yeast Mold Rapid is AOAC PTM validated and can detect yeast and molds in cannabis in as little as 72 hours. CompactDry is incredibly easy to use, convenient, and makes microbial testing a breeze. Call for pricing. Cloudious9 Atomic9 Vaporizer — With breakthrough patent-pending Dual Layer heating technology, this device is one of the smallest and most economical convection quality vaporizers ever made. The device has six adjustable temperatures, a rapid vapor cooling chamber, full access cleaning, and a nifty retractable herb shovel for convenience. The pocket-sized vape, which comes in both black and gray, contains a one button user interface and heats in 30-45 seconds. $60



